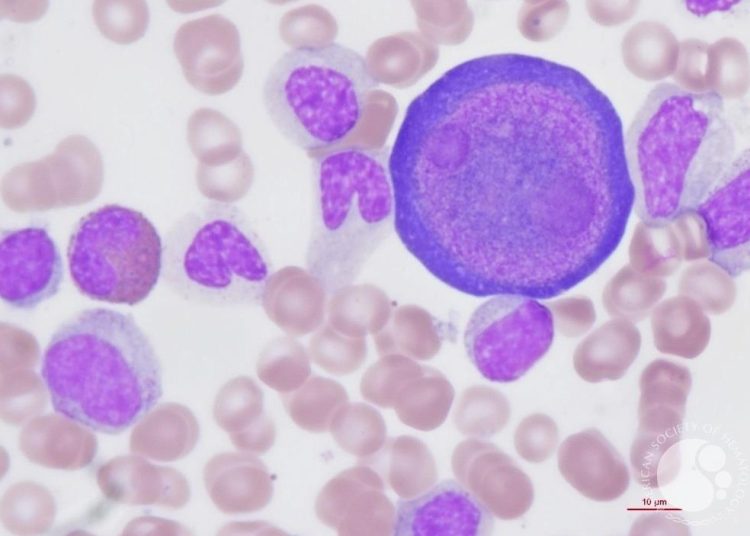
Προσοχή στον Παρβοϊό: Τι να γνωρίζουν γονείς & παιδιά

Συγκλονισμένο παραμένει το πανελλήνιο και εξαιρετικά ανήσυχοι οι γονείς, μετά την τραγική είδηση ότι ένα παιδί 3,5 ετών έχασε τη ζωή του από οξεία μυοκαρδίτιδα που του προκάλεσε λοίμωξη από παρβοϊό (ParvovirusB19).
Στον παιδικό σταθμό που φοιτούσε το νήπιο στη Θεσσαλονίκη παρουσιάστηκαν συνολικά έντεκα κρούσματα, ένα παιδάκι νοσηλεύτηκε σε νοσοκομείο της Αθήνας και είναι πλέον καλά στην υγεία του, ενώ άλλα επτά παιδάκια από την ευρύτερη περιοχή νοσηλεύονται στο Ωνάσειο.
Σύμφωνα με τον παιδίατρο Μάριο Ανδρέου, πρόκειται για έναν ιό που υπάρχει εδώ και χρόνια και ο οποίος εμφανίζει συμπτώματα ήπιας λοίμωξης. Παρ’ όλα αυτά υπάρχει ένα χαρακτηριστικό που τον διαφοροποιεί από μια απλή λοίμωξη όσον αφορά στη συμπτωματολογία και το οποίο προσομοιάζει με σύμπτωμα των μαγουλάδων.
«Είναι ένας ιός που υπάρχει εδώ και χιλιάδες χρόνια, δεν είναι κάτι καινούργιο. Πάντα βλέπαμε παρβοϊούς και πάντα βλέπαμε τη λεγόμενη πέμπτη νόσο. Δηλαδή πέρα από την ιλαρά, την ερυθρά, την ανεμοβλογιά και την οστρακιά, είχαμε και την πέμπτη νόσο που οφειλόταν σε αυτόν τον ιό. Σε έναν ιό κυτταροτοξικό, Β19, έτσι λέγεται» λέει ο κ. Ανδρέου μιλώντας στον ΣΚΑΪ.
Όπως εξηγεί ο ίδιος, αν κολλήσει κάποιος από άλλο άτομο – υπάρχει και παρβοϊός στις γάτες και στους σκύλους αλλά δεν έχει σχέση -, σε μία με δύο εβδομάδες παρουσιάζει μια ήπια λοίμωξη, σαν ένα κοινό κρυολόγημα, με μυαλγία και πονοκέφαλο.
Το χαρακτηριστικό που κάνει ο Β19 είναι ότι αυτός που έχει κολλήσει «βγάζει ένα εξάνθημα στο πρόσωπο – και στη συνέχεια στον κορμό -, σαν να έχει δεχθεί μια έντονη σφαλιάρα, ένα ράπισμα» προσθέτει ο κ. Ανδρέου διευκρινίζοντας ότι δεν είναι σύμπτωμα που εμφανίζουν όλα τα παιδιά.
Έτσι βγαίνει και η διάγνωση «γιατί δεν υπάρχουν άλλα χαρακτηριστικά ευρήματα για να το καταλάβεις» συνεχίζει ο ίδιος.
Σύμφωνα με τον κ. Ανδρέου, «όλος ο ενήλικος πληθυσμός ενδέχεται να το έχει περάσει γι’ αυτό έχουμε αντισώματα της τάξης του 60%. Ένα ποσοστό 20-30% – και μάλιστα των γυναικών – δεν το έχει περάσει». Ερωτηθείς εάν υπάρχει εμβόλιο, απάντησε αρνητικά.
Σε άλλο σημείο ο κ. Ανδρέου τόνισε ότι το πρόβλημα είναι ότι όταν εμφανίζεται «το εξάνθημα το παιδί δεν μεταδίδει το νόσημα. Το έχει μεταδώσει πριν».
«Επιπλοκές κάνει σε σπάνιες περιπτώσεις» σύμφωνα με τον κ. Ανδρέου. «Προσβάλλει τις αρθρώσεις κυρίως στους ενήλικες και κάνει αρθρίτιδα. Ο ιός χτυπά τους πάντες. Σε σπάνιες περιπτώσεις κάνει καρδίτιδα, όπως όλες οι ιώσεις. Δεν υπάρχει ιός που να μην προσβάλλει το μυοκάρδιο. Όταν υπάρχει και άλλες συνλοιμώξεις, ο ιός βρίσκει ευκαιρία και κάνει μεγαλύτερη ζημιά», εξηγεί.
Στη συνέχεια ο κ. Ανδρέου επισήμανε την περίπτωση των εγκύων, λέγοντας ότι ο ιός προσβάλλει τις γυναίκες που κυοφορούν. «Οι έγκυοι όταν προσβληθούν στο πρώτο, δεύτερο ή το τρίτο τρίμηνο ή θα κάνουν βαριά αναιμία ή το μωρό θα κάνει κι αυτό αναιμία ή και θα γεννηθεί νεκρό. Μπορεί να δημιουργήσει προβλήματα στη μετέπειτα ζωή του βρέφους».
Παγώνη: Το πρόβλημα είναι οι επιπλοκές
«Δεν είναι κάτι φοβερό ο παρβοϊός, τον γνωρίζουμε», λέει μιλώντας στο MEGA η πρόεδρος της ΕΙΝΑΠ, Ματίνα Παγώνη.
Όπως εξήγησε η κ. Παγώνη, τα συμπτώματα είναι του απλού κρυολογήματος – βήχας, πυρετός, αδιαθεσία, πονόλαιμος, εξάνθημα το οποίο είναι χαρακτηριστικό στα παιδιά, στα μάγουλα.
Ο ιός μεταδίδεται με τα σταγονίδια, με την επαφή. «Αυτό που φοβόμαστε όλοι είναι οι επιπλοκές που κάνει. Αυτό που έκανε με το κοριτσάκι, τη μυοκαρδίτιδα, μπορεί να κάνει και περικαρδίτιδα».
Η πρόεδρος του ΕΙΝΑΠ συστήνει σε όλους ψυχραιμία και προσοχή: «Δεν χρειάζεται πανικός, είναι σε εξάρσεις και υφέσεις. Χρειάζεται προσοχή. Δεν υπάρχει συγκεκριμένο εμβόλιο, όμως ανάλογα με τη συμπτωματολογία αντιμετωπίζεται».
Οδηγίες ΕΟΔΥ προς παιδιάτρους
Ειδοποίηση στους παιδιάτρους όλης της χώρας έστειλε ο ΕΟΔΥ μετά τα κρούσματα παρβοϊού στο νηπιαγωγείο – παιδικό σταθμό της Θεσσαλονίκης, όπου το 3,5 ετών νήπιο έχασε τη ζωή του από επιπλοκές.
Οι γιατροί καλούνται να λαμβάνουν υπόψη τον κίνδυνο μυοκαρδίτιδας δύο εβδομάδες μετά τη λοίμωξη από τον παρβοϊό Β19.
Ιδιαίτερη προσοχή συνιστάται στις εγκύους λόγω κινδύνου σοβαρών επιπλοκών για το έμβρυο, καθώς και όσοι πάσχουν από αναιμία ή βρίσκονται σε ανοσοκαταστολή.
Σύμφωνα με την Κλινική Mayo, η λοίμωξη από B19 είναι μια κοινή και άκρως μεταδοτική παιδική ασθένεια που συνήθως δεν απαιτεί επίσκεψη σε γιατρό. Εμφανίζεται έπειτα από περίοδο επώασης 4 έως 14 ημερών, όμως ένα στα πέντε κρούσματα δεν εμφανίζει καθόλου συμπτώματα.
Για τους υπόλοιπους η νόσος ξεκινά με πυρετό, πονοκέφαλο, γαστρεντερικές διαταραχές και ρινόρροια, ενώ αργότερα εμφανίζεται το χαρακτηριστικό, ζωηρό εξάνθημα στα μάγουλα. Το κοκκίνισμα μπορεί στη συνέχεια να επεκταθεί στο υπόλοιπο σώμα.
Από τον παρβοϊό Β19 προσβάλλονται και οι ενήλικες, όμως σε αυτή την περίπτωση το εξάνθημα συνήθως απουσιάζει και το κύριο σύμπτωμα είναι ο πόνος στις αρθρώσεις που διαρκεί μέρες ή εβδομάδες.
Επίσκεψη σε γιατρό απαιτείται για τις εγκύους και ασθενείς με δρεπανοκυτταρική αναιμία ή προβλήματα στο ανοσοποιητικό σύστημα.
Αύξηση κρουσμάτων
Σύμφωνα με τον ΕΟΔΥ, χώρες της Ευρώπης όπως η Γαλλία, η Ολλανδία, η Ιρλανδία, η Δανία και Νορβηγία αναφέρουν από τα τέλη του 2023 αύξηση των κρουσμάτων σε παιδιά και εγκύους.
«Στη Γαλλία καταγράφεται επίσης αύξηση στις αποβολές, τις αμβλώσεις και στους θανάτους σε νεογνά, λόγω περιγεννητικής λοίμωξης από παρβοϊό» σημειώνεται στην ανακοίνωση.
«Η λοίμωξη τις πρώτες 20 εβδομάδες της εγκυμοσύνης μπορεί να οδηγήσει σε σοβαρή ανεπιθύμητη έκβαση για το έμβρυο, όπως ο εμβρυϊκός ύδρωπας και ο ενδομήτριος θάνατος σε έως και 10% των περιπτώσεων».
Τα δύο τρίτα του πληθυσμού εκτιμάται ότι έχουν ανοσία λόγω προηγούμενης λοίμωξης, ωστόσο η επαναλοίμωξη δεν αποκλείεται.